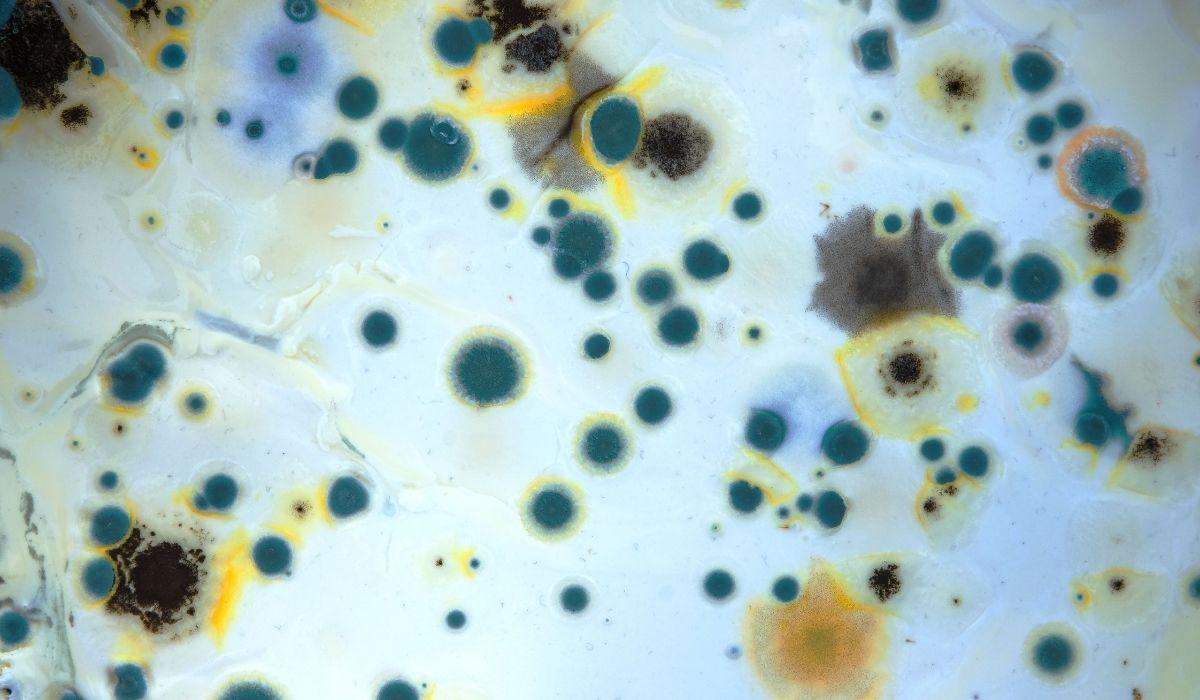
mold chemicals on the wall

Why Mold Happens After a Fire (Water from Hoses + Humidity)
A house fire is scary. But what many people don’t expect is what happens after the flames are out. Firefighters often use a lot of water to stop the fire. That water can soak into walls, floors, insulation, and ceilings. When things stay wet, mold can grow fast.
In the first 24–48 hours, mold spores can begin to spread on wet building materials. That’s why fire and water damage restoration should happen quickly. If you need help with smoke, fire, and water cleanup, you can learn more about fire damage restoration Orange County here.
Mold after fire water damage is common, but it can be stopped with the right steps.

Why Mold Grows So Fast After a Fire
Mold needs just a few things to grow:
- Moisture (from firefighting water, broken pipes, or sprinklers)
- Warm temperatures (homes are often warm, even after a fire)
- Food sources (drywall, wood, carpet, dust, and soot)
- Time (mold can start quickly if wet materials stay wet)
After a fire, homes can also have high humidity from wet materials and poor airflow. Smoke damage can also leave behind soot and particles that mix with moisture. This can make cleanup harder and increase contamination.
Signs You Might Have Mold After Fire Water Damage
Mold is not always easy to see right away. Fire damage can hide moisture inside walls and under floors. Watch for these warning signs:
Musty Smell That Won’t Go Away
A strong, damp smell is a common sign of hidden mold growth.
Visible Spots or Stains
You may see green, black, white, or brown spots on:
- Drywall
- Baseboards
- Ceilings
- Wood framing
- Carpet edges
Soft or Warped Materials
Wet drywall can feel soft. Wood floors may buckle. Paint may bubble.
More Allergy-Like Symptoms
Some people feel:
- Sneezing
- Coughing
- Itchy eyes
- Headaches
- Trouble breathing (especially with asthma)
If symptoms get worse inside the home, mold and indoor air quality problems may be part of the cause.
Where Mold Hides After a Fire
Fire water can travel farther than you think. Mold often grows in places like:
- Behind drywall and inside wall cavities
- Under carpet and padding
- Under baseboards
- In insulation
- In crawl spaces and attics
- Around windows and doors
- Under cabinets and vanities
- Inside HVAC ducts (if water or smoke got pulled into the system)
Even if the surface looks dry, moisture can still be trapped deeper inside.
Why DIY Cleanup Is Risky After Fire and Water Damage
After a fire, the home may contain:
- Soot and smoke residue
- Ash and debris
- Contaminated water (sometimes from outside sources)
- Mold spores that spread easily
If you scrub or tear out materials the wrong way, you can spread mold into clean areas. Using fans without proper containment can blow spores through the home. And mixing smoke residue with water can create sticky, hard-to-clean surfaces.
For safety, it helps to have trained restoration professionals who know how to handle fire, water, and mold together.
What To Do Immediately If You Suspect Mold
Here are smart steps you can take right away (as long as the home is safe to enter):
Stop the Water Source (If It’s Still Leaking)
If a pipe broke or the roof was damaged, stop the leak as soon as possible.
Improve Airflow
If electricity is safe, you can:
- Open windows (if outdoor air is clean)
- Run bathroom fans
- Run a portable fan pointing OUT a window (to push damp air out)
Remove Small Wet Items
Move damp items like rugs, pillows, or clothing to a dry area. If they smell smoky, keep them separated.
Avoid Disturbing Moldy Areas
Don’t scrape, sand, or rip out materials if you see mold. That can release spores.
Document Damage for Insurance
Take photos of:
- Water damage
- Mold growth
- Smoke/soot staining
- Damaged drywall, ceilings, floors, and belongings
This can help with an insurance claim and speed up approvals for renovation and repairs.
Professional Mold Cleanup After Fire Water Damage
Mold after fire water damage needs a plan that includes drying, cleaning, and safe removal. A professional restoration team often follows steps like these.
Inspection and Moisture Testing
A technician checks for hidden moisture using:
- Moisture meters
- Thermal imaging (in some cases)
- Visual inspection of drywall, ceiling, and flooring
The goal is to find wet spots before they become bigger mold problems.
Water Extraction and Drying
If water is still present, crews remove it using extraction tools. Then they set up drying equipment like:
- Air movers
- Dehumidifiers
- HEPA air scrubbers (to help clean the air)
Drying is not just about “feeling dry.” The materials must reach safe moisture levels.
Containment to Stop Spread
If mold is present, the work area may be sealed using plastic barriers. This helps keep spores from spreading to clean rooms.
HEPA Filtration and Air Cleaning
HEPA filters can capture tiny particles, including mold spores and smoke particles. This supports healthier indoor air quality during cleanup.
Removal of Damaged Materials
Some materials cannot be saved, such as:
- Moldy drywall
- Wet insulation
- Carpet padding
- Warped wood materials
Safe removal helps stop regrowth.
Cleaning and Treatment
Surfaces may be cleaned with professional methods and antimicrobial products where appropriate. Smoke and soot cleanup may happen at the same time, because fire residue can cling to surfaces and cause odor.
Repairs and Renovation
After cleanup, the home may need:
- New drywall
- New flooring
- Painting and sealing
- Ceiling repairs
- Replacing cabinets or trim
A restoration team can help manage the project so the home is safe and looks right again.
How Long Does Mold Take To Grow After Fire Water Damage?
Mold can begin growing within 24 to 48 hours when materials stay wet. In a few days, the growth can spread and get deeper into porous materials like drywall and wood.
That’s why quick drying and professional restoration matters.
Does Homeowners Insurance Cover Mold After Fire Water Damage?
Sometimes, yes. Coverage often depends on:
- The cause of the water damage (like firefighting water)
- How quickly the damage was reported
- The policy terms and mold limits
- Whether the mold was “sudden and accidental” versus long-term neglect
Here are helpful tips for insurance:
Report the Damage Quickly
Call your insurance company as soon as you can. Late reporting can cause delays.
Keep Records
Save:
- Photos and videos
- Receipts for temporary repairs
- Notes about dates and conversations
Ask About Mold Limits
Some policies limit mold coverage. Even then, fire-related water damage may still be covered under certain parts of the policy.
A restoration company like Preferred Restoration can also provide documentation that supports your claim.
How To Prevent Mold During Fire Damage Cleanup
Prevention is easier than removal. If your home had fire and water damage, these steps help reduce mold risk:
Dry the Structure Fast
Drying the home quickly is the #1 way to stop mold. Wet drywall and wet wood need proper airflow and dehumidification.
Control Humidity
Mold loves humidity. Keeping indoor humidity lower helps stop growth.
Remove Wet Porous Materials Early
If carpet padding or insulation is soaked, it may need to be removed to prevent mold.
Clean Soot and Smoke Residue
Smoke particles and soot can cling to surfaces and mix with moisture. Proper cleaning helps reduce odors and grime that can support microbial growth.
When You Should Call Preferred Restoration
You should reach out for professional help if:
- You see mold growth
- You smell a musty odor days after the fire
- Drywall or ceiling feels soft or swollen
- Floors are warping or bubbling
- You’re dealing with both smoke damage and water damage
- You want help with the insurance process and repair planning
Mold after fire water damage can get worse quickly. Getting the right restoration plan early can save time, money, and stress.
Mold After Fire Water Damage FAQs
What causes mold after a house fire?
Mold grows when firefighting water or leaks soak into materials like drywall, wood, carpet, and insulation. If the home stays wet, mold can start within 1–2 days.
How can I tell if mold is behind the drywall?
Common signs include a musty smell, bubbling paint, soft drywall, stains, or higher allergy symptoms indoors. Moisture testing can confirm hidden water.
Can I clean mold after fire water damage myself?
Small surface spots may seem easy to clean, but fire damage often hides moisture and contamination. Scrubbing can spread spores. Professional containment and drying are safer.
How do professionals remove mold after fire water damage?
They inspect, dry the structure, set up containment, use HEPA air filtration, remove damaged materials, clean surfaces, and repair the home to prevent mold from returning.
Will mold come back after remediation?
Mold can return if moisture is not fully fixed. Proper drying, humidity control, and repairs to leaks or wet materials are key to long-term results.


